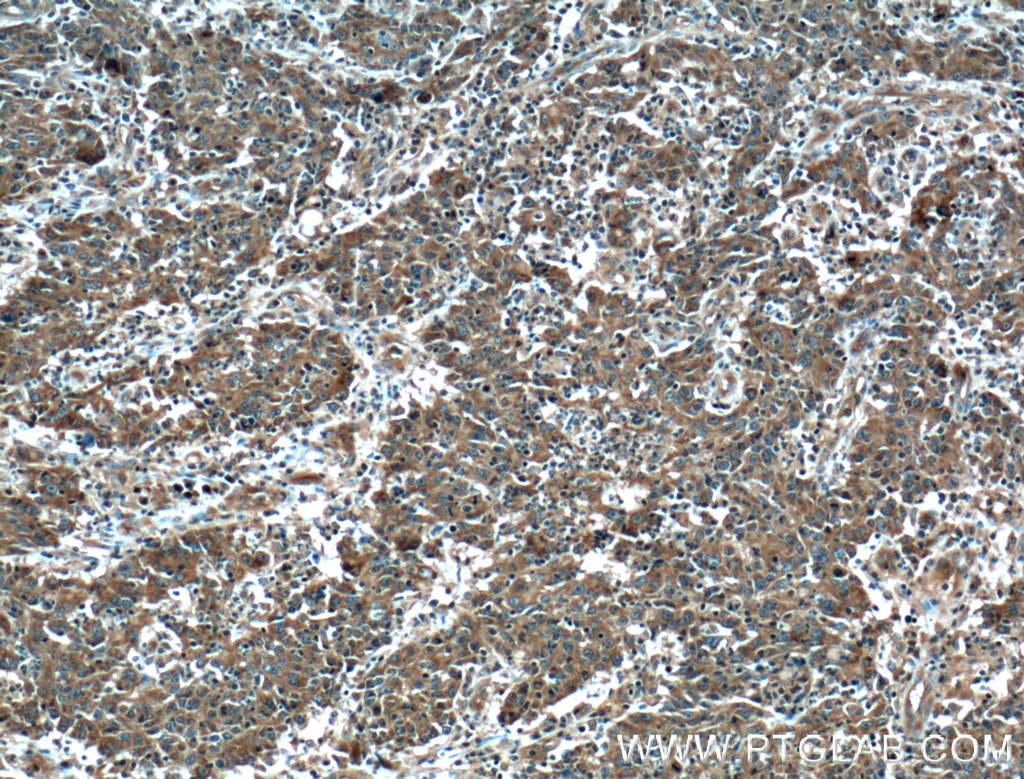
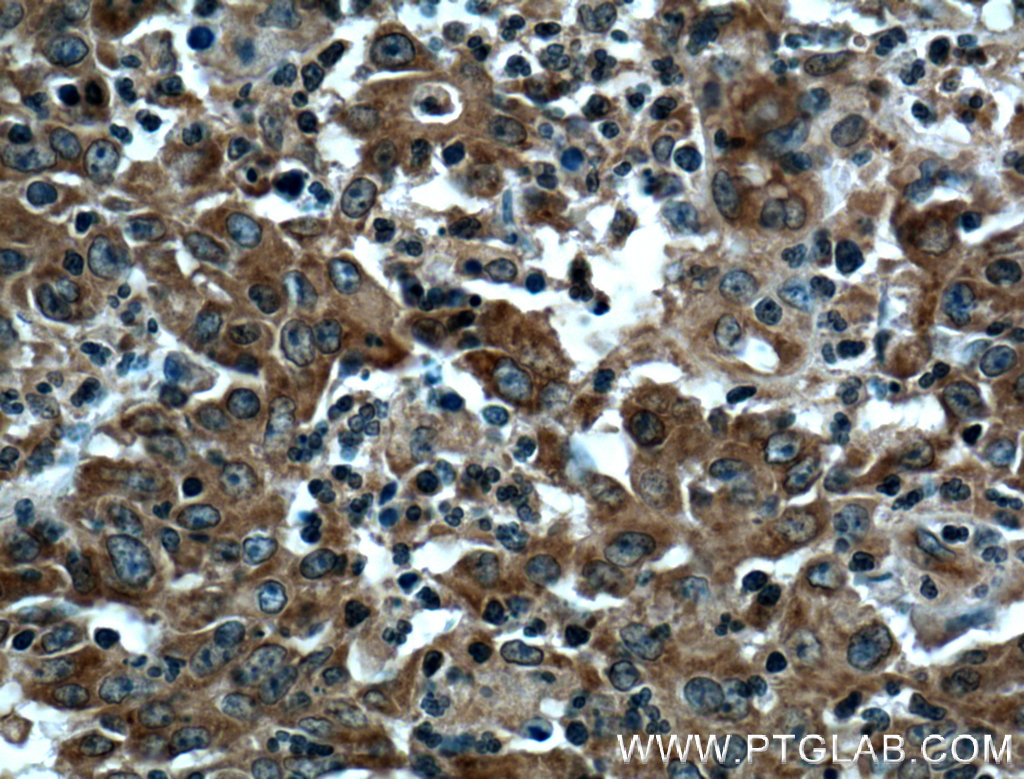

验证数据展示
经过测试的应用
| Positive WB detected in | mouse skeletal muscle tissue, RAW 264.7 cells, mouse heart tissue, SH-SY5Y cells |
| Positive IP detected in | mouse brain tissue |
| Positive IHC detected in | human colon cancer tissue, human cervical cancer tissue Note: suggested antigen retrieval with TE buffer pH 9.0; (*) Alternatively, antigen retrieval may be performed with citrate buffer pH 6.0 |
| Positive IF/ICC detected in | SH-SY5Y cells |
| Positive FC (Intra) detected in | HeLa cells |
推荐稀释比
| 应用 | 推荐稀释比 |
|---|---|
| Western Blot (WB) | WB : 1:1000-1:8000 |
| Immunoprecipitation (IP) | IP : 0.5-4.0 ug for 1.0-3.0 mg of total protein lysate |
| Immunohistochemistry (IHC) | IHC : 1:50-1:500 |
| Immunofluorescence (IF)/ICC | IF/ICC : 1:50-1:500 |
| Flow Cytometry (FC) (INTRA) | FC (INTRA) : 0.25 ug per 10^6 cells in a 100 µl suspension |
| It is recommended that this reagent should be titrated in each testing system to obtain optimal results. | |
| Sample-dependent, Check data in validation data gallery. | |
产品信息
13422-1-AP targets PPP3CA in WB, IHC, IF/ICC, FC (Intra), IP, ELISA applications and shows reactivity with human, mouse samples.
| 经测试应用 | WB, IHC, IF/ICC, FC (Intra), IP, ELISA Application Description |
| 文献引用应用 | WB, IHC, IF |
| 经测试反应性 | human, mouse |
| 文献引用反应性 | human, mouse, pig, monkey, chicken |
| 免疫原 |
CatNo: Ag4203 Product name: Recombinant human PPP3CA protein Source: e coli.-derived, PGEX-4T Tag: GST Domain: 3-302 aa of BC025714 Sequence: EPKAIDPKLSTTDRVVKAVPFPPSHRLTAKEVFDNDGKPRVDILKAHLMKEGRLEESVALRIITEGASILRQEKNLLDIDAPVTVCGDIHGQFFDLMKLFEVGGSPANTRYLFLGDYVDRGYFSIECVLYLWALKILYPKTLFLLRGNHECRHLTEYFTFKQECKIKYSERVYDACMDAFDCLPLAALMNQQFLCVHGGLSPEINTLDDIRKLDRFKEPPAYGPMCDILWSDPLEDFGNEKTQEHFTHNTVRGCSYFYSYPAVCEFLQHNNLLSILRAHEAQDAGYRMYRKSQTTGFPSL 种属同源性预测 |
| 宿主/亚型 | Rabbit / IgG |
| 抗体类别 | Polyclonal |
| 产品类型 | Antibody |
| 全称 | protein phosphatase 3 (formerly 2B), catalytic subunit, alpha isoform |
| 别名 | CALNA, Calcineurin A alpha, Calmodulin-dependent calcineurin A subunit alpha isoform, CALN, CALNA1 |
| 计算分子量 | 59 kDa |
| 观测分子量 | 59 kDa |
| GenBank蛋白编号 | BC025714 |
| 基因名称 | PPP3CA |
| Gene ID (NCBI) | 5530 |
| RRID | AB_2168314 |
| 偶联类型 | Unconjugated |
| 形式 | Liquid |
| 纯化方式 | Antigen affinity purification |
| UNIPROT ID | Q08209 |
| 储存缓冲液 | PBS with 0.02% sodium azide and 50% glycerol, pH 7.3. |
| 储存条件 | Store at -20°C. Stable for one year after shipment. Aliquoting is unnecessary for -20oC storage. |
背景介绍
PPP3CA, also called calcineurin Aα, is the only serine/threonine protein phosphatase under the control of Ca2+/calmodulin, and plays a critical role in the coupling of Ca2+ signals to cellular responses. Ca2+ signaling plays a central role in hypertrophic growth of cardiac and skeletal muscle in response to mechanical load and a variety of signals. Therefore, PPP3CA plays an important role in muscle differentiation, especially in muscle fiber type conversion. It is also involved in osteoclast regulation, regulating bone formation through an effect on osteoblast differentiation.
实验方案
| Product Specific Protocols | |
|---|---|
| FC protocol for PPP3CA antibody 13422-1-AP | Download protocol |
| IF protocol for PPP3CA antibody 13422-1-AP | Download protocol |
| IHC protocol for PPP3CA antibody 13422-1-AP | Download protocol |
| IP protocol for PPP3CA antibody 13422-1-AP | Download protocol |
| WB protocol for PPP3CA antibody 13422-1-AP | Download protocol |
| Standard Protocols | |
|---|---|
| Click here to view our Standard Protocols |
发表文章
| Species | Application | Title |
|---|---|---|
Mol Psychiatry A recurrent SHANK1 mutation implicated in autism spectrum disorder causes autistic-like core behaviors in mice via downregulation of mGluR1-IP3R1-calcium signaling. | ||
J Adv Res Transducin-like enhancer of split 3 protects against lipopolysaccharide-induced inflammation through DDX5-ATF1-PPP2R5A signaling | ||
Proc Natl Acad Sci U S A Major contribution of the 3/6/7 class of TRPC channels to myocardial ischemia/reperfusion and cellular hypoxia/reoxygenation injuries. | ||
J Agric Food Chem Dietary Taurine Supplementation Improves the Meat Quality, Muscle Fiber Type, and Mitochondrial Function of Finishing Pigs | ||
J Cell Physiol Taurine promotes muscle fiber type transformation through CaN/NFATc1 signaling in porcine myoblasts | ||
Neurobiol Dis Calcineurin β protects brain after injury by activating the unfolded protein response. |